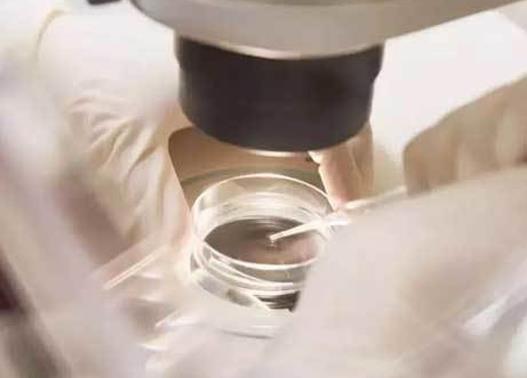
国内做三代试管是合法的吗，选择正规机构是合法的

国内做三代试管是合法的吗,选择正规机构是合法的
更新时间:2023-11-03
人们总是渴望了解有关试管助孕的知识,以便了解它的合法性。试管助孕是指由一位受聘的有经验的医生帮助一对夫妻或单身女性把外界的卵子植入他们的子宫以实现母亲怀孕的技术。这种技术被广泛应用于偏远地区,以满足缺乏本地卵子供体的需求。
试管助孕在某些地区是合法的。在国内,根据《国内人口与计划生育法》的规定,试管助孕合法。但是试管助孕是由政府严格控制的,仅限于有许可证的试管助孕试管医院。在美国,试管助孕是合法的,但是在不同的州有不同的规定。
试管助孕不是没有风险的。如果接受试管助孕的女性或夫妻没有正确接受和理解安全性课程,她们就可能面临一些风险。其中一些风险助孕括:可能会出现超过2个胎儿的风险,也可能会出现胚胎异位妊娠的风险,这是一种危及民主和胎儿的严重后果。
试管助孕的费用也相当昂贵。大多数人无法承受试管助孕的费用,因为它可能需要数千美元。此外由于临床试验的改变和药物的增加,这种技术的费用还在上涨。
试管助孕也会带来一些道德风险。有些人认为,试管助孕违反了道德准则,因为它破坏了生命的自然规律。
小提示:综上所述,试管助孕是否合法取决于地区,存在一定的风险和费用,也可能会带来道德风险。在决定是否接受试管助孕之前,夫妻或单身女性应该考虑到所有的风险和后果,并咨询专业的医生,以便作出正确的决定。
以上就是医院招聘网小编为大家整理的《国内做三代试管是合法的吗,选择正规机构是合法的》相关信息,希望大家喜欢。
针灸对试管移植着床有帮助吗?来看看研究结果 郑州医院做试管婴儿哪个医生好?这些医生值得你信任 试管婴儿是只有成功了才会收费吗? 试管要做几次才能成功?这些方法或许能提高成功率 试管移植后着床的表现有哪些?这些细节需要了解 贵州试管医院排名比较好的医院,打破不孕不育难题 想要在长沙做试管婴儿,但不知道价格怎么算?这篇文章告诉你 青岛试管的费用大概是多少?这四点因素会影响价格
内容版权声明:本网站部分内容由网上整理转发,如有侵权请联系管理员进行删除.